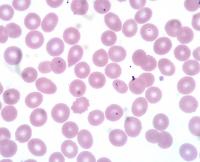

Infectious Disease

Combating Malnutrition in HIV-infected Children in South Africa
Severe malnutrition is a common first presentation of HIV in resource-poor areas of the world. Infectious disease specialist Philip LaRussa, MD is collaborating with researchers at the University of Kwa Zulu Natal in Durban, South Africa to study malnourished infants and children who are infected with HIV. The collaborators recently published research on the effects of severe malnourishment on mortality and immunological recovery following the initiation of antiretroviral therapy. They theorized that severely malnourished children may not be capable of fully absorbing antiretroviral therapy while they are recovering from severe acute malnutrition, because poor absorption may lead to lower drug levels and increase the risk of drug resistance and poor initial response to therapy. They found that severe malnutrition is associated with a worse prognosis and impaired immune recovery in HIV-infected children on antiretroviral therapy. In a second study the researchers are investigating the immunologic response to childhood immunizations in HIV-infected children who are in various stages of treatment with antiretroviral therapy. This investigation should help determine whether these children must be revaccinated when they are further along in the immune recovery that follows institution of antiretroviral therapy.
Contact
Phil LaRussa
psl1@cumc.columbia.edu
Malaria and its Effects on Iron Absorption and Neurologic Health
A quarter of the world’s clinical attacks of malaria occur in southeast Asia, where nearly a billion people have been exposed to the disease. Among other problems, acute infection with the protozoa Plasmodium falciparum — the form of malaria with the highest rates of complications and mortality — affects the absorption, pharmacokinetics, and metabolism of iron, which is particularly important in women of childbearing age. In collaboration with Switzerland's Institut Merieux, Gary Brittenham, MD is undertaking research with colleagues in Thailand and Kenya to measure iron absorption during and after successful treatment of acute uncomplicated falciparum malaria. The research will assess the effects of the disease on iron metabolism and determine its effect on absorption of iron from iron supplements and other iron interventions. Dr. Brittenham is also working with Thai colleagues to research the neuropathological consequences of this form of malaria, with the goal of developing strategies to prevent persistent neurological disorders.
Contact
Gary Brittenham, MD
gmb31@cumc.columbia.edu
Using Technology to Improve Immunization Coverage
Vaccines are one of the most effective measures against disease, yet there are still many barriers between highly effective vaccines and high vaccination coverage worldwide. Melissa Stockwell, MD, MPH is researching the use of emerging communication technologies such as text messaging to promote healthy behaviors around vaccination. Dr. Stockwell is collaborating with researchers from Australia to explore attitudes toward influenza and pertussis vaccination and the use of text message reminders during pregnancy. Along with Betsy Pfeffer, MD and Phil LaRussa, MD, she is also collaborating with investigators in Uganda around communication about HPV vaccination.
Contact
Melissa Stockwell, MD, MPH
mss2112@cumc.columbia.edu